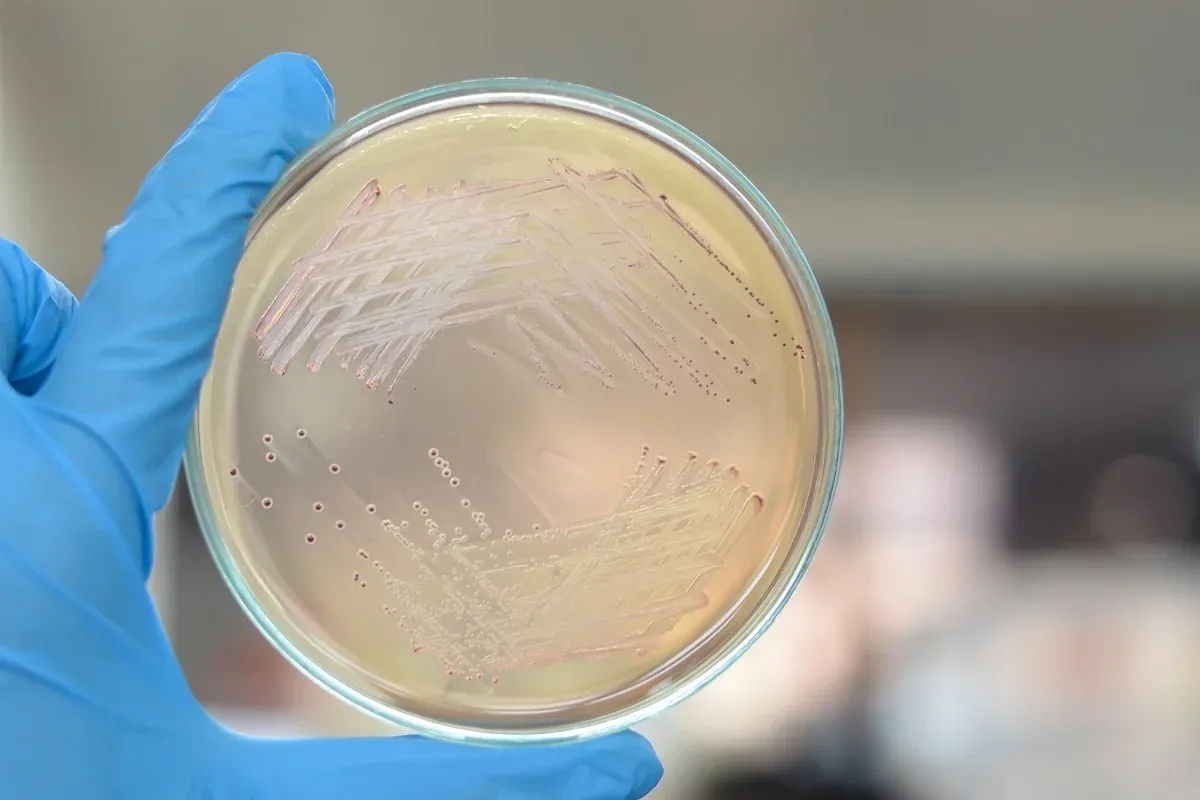

1 enterococcus faecalis
Баира дугарова звезда кочевника
Обречены ютуб
Честер не страшно
Дзержинск нижегородская область драмтеатр афиша
Ершово 51а
Шуйский ситец фото
Терапевты 3 поликлиники краснодар
Кто зачем пришел на свадьбу
Мод бименджи драйв тойота краун
Последствия смещения позвонков
Какие в этом тексте орфограммы
Коляска cybex priam iv rose gold
Погода в вакиярово на 10 дней
1 enterococcus faecalis 106 фото